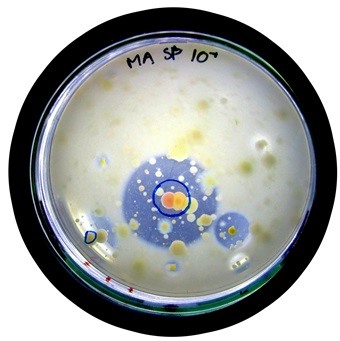

Forløb: Ekstremt liv
Introduktion: Livet har gennem de sidste 3,8 milliarder år udviklet sig til den mangfoldighed af levende organismer, der findes på Jorden i dag. Naturen har i denne proces fundet smarte løsninger til de udfordringer, som organismerne har stået over for, og gennem naturlig udvælgelse er disse mekanismer blevet optimeret. Det har betydet, at livet har været i stand til at kolonisere alle egne af kloden, selv de steder hvor forholdene er så ugæstfrie og barske, at man aldrig ville tro, at nogen levende organismer ville kunne overleve. Det er netop organismer, der lever i sådanne ekstreme miljøer, der er omdrejningspunktet for dette materiale.
Vi vil se nærmere på to forskellige former for ”ekstremt liv”, nemlig ekstremofile bakterier og de mikroskopiske bjørnedyr. De kan blandt andet findes dybt nede i indlandsisen i Grønland, i varme termiske søer, i knastørre ørkener og sågar i områder med stærk stråling fra radioaktive stoffer. Men hvordan bærer de sig egentlig ad med at overleve sådanne steder? Og kan disse små organismer lære os mennesker noget, vi kan bruge til at løse nogle af de udfordringer, som vores samfund står over for i dag?
Svarene på disse spørgsmål, sammen med uddybende beskrivelser af de to ekstreme organismer, kan du finde i teoriafsnittene. Derudover indeholder materialet to forsøg, ”Find dit eget bjørnedyr” og ”Find enzymer til miljøvenligt vaskepulver”.
God fornøjelse med materialet!

Figur 1. Bjørnedyr er mikroskopiske dyr, der kan leve under ekstreme forhold.
Teori:
Ved at forstå naturen og de organismer som lever der, kan vi mennesker hente inspiration til nye produkter og løsninger til gavn for det samfund, vi lever i. Livet på Jorden har eksisteret i omkring 3,8 milliarder år, og i løbet af den tid har de levende organismer udviklet et væld af mekanismer for at imødegå de udfordringer, som de har stået overfor. Naturen kan dermed ses som et kæmpe opslagsværk med bæredygtige løsninger, der er optimeret gennem mange, mange års udvælgelse. I stedet for at opfinde alting fra bunden af, vil det derfor være smart at hente nye idéer i naturen og efterligne dens løsninger. Dette felt kaldes på fagsprog ”bionik” og har allerede givet anledning til adskillige nye opfindelser og produkter. I de tre undervisningsfilm, som findes under fanen “Film om bionik”, bliver der set nærmere på forskellige eksempler på anvendelsen af netop bionik. Filmene er lavet af AlphaFilm & Kommunikation i samarbejde med DTU Systembiologi og Biotech Academy.
Disse film indeholder mange fascinerende eksempler på, hvordan naturen kan være vores læremester. I dette projekt ser vi nærmere på to af dem, nemlig ekstremofile bakterier og bjørnedyr. De beskrives i henholdsvis filmen ”Naturen – bioteknologiens skatkammer” og ”Naturen – en genial opfinder”. Begge disse organismer er fascinerende former for liv, som kan overleve under ekstremt barske forhold. Det er derfor interessant at dykke ned i mekanismerne bag deres utrolige overlevelsesevne og undersøge nærmere, hvad vi kan lære af dem.
Teoriafsnittet er således delt op i to overordnede dele, en om ekstremofile bakterier og en om bjørnedyr. Under hver hoveddel findes en række afsnit med beskrivelser af de to organismer. Først kigger vi på de ekstremofile bakterier og dernæst bjørnedyrene. De to overordnede dele kan læses uafhængigt af hinanden, men det anbefales dog at læse afsnittene inden for hver hoveddel i den givne rækkefølge.
Film om bionik:
Disse film indeholder mange fascinerende eksempler på, hvordan naturen kan være vores læremester. I dette projekt ser vi nærmere på to af dem, nemlig ekstremofile bakterier og bjørnedyr. De beskrives i henholdsvis filmen ”Bioteknologiens skatkammer” og ”En genial opfinder”. Begge disse organismer er fascinerende former for liv, som kan overleve under ekstremt barske forhold. Det er derfor interessant at dykke ned i mekanismerne bag deres utrolige overlevelsesevne og undersøge nærmere, hvad vi kan lære af dem.
Rigtig god fornøjelse!
Øvelser:
Der er udviklet et forsøg til hver af de to dele af materialet, og du kan således lave et forsøg omhandlende bjørnedyr og et om ekstremofile bakterier.
”Find enzymer til miljøvenligt vaskepulver”
”Find dit eget bjørnedyr”
Videoer hørende til forsøget med bjørnedyr er dog taget ud af den printvenlige forsøgsvejledning, så det anbefales, at du læser den her på hjemmesiden.
Materialer
- En lille håndfuld mos fra eksempelvis en græsplæne, et træ eller en sten.
- Stereomikroskop, der minimum kan forstørre 30 gange, men gerne omkring 50-60 gange.
- Petriskåle (1-2 stk. pr. gruppe).
- En sort skive pap så petriskålen kan stå på en sort baggrund, når der ledes efter bjørnedyr med stereomikroskopet. Nogle stereomikroskoper har i forvejen et sort underlag, og så behøves sort pap ikke.
- Lyskilde, for eksempel en kraftig lommelygte til at lyse mosprøven op fra siden, når der ledes efter bjørnedyr med stereomikroskopet. Nogle stereomikroskoper har i forvejen bevægelige lys-arme på hver side af mikroskopet, og så behøves der ikke en ekstra lyskilde.
- Lille digitalkamera eller mobiltelefon med kamera.
Fremgangsmåde
Forberedelse
-
- En elev fra hver gruppe samler lidt mos (en lille håndfuld er rigeligt) fra en have, en skov eller en park. Det kan typisk findes i græsplæner, på sten eller på træer. Tag gerne mos fra yderkanten af en mospude eller fra de mest grønne områder. Prøv at undgå at få for meget jord med. Det kan gøres ved kun at hive den øverste del af mosset af, når det plukkes eller ved at rive de jordede rødder af bagefter. Den indsamlede mos lægges i en konvolut, en lille plastpose eller en boks. For at der ikke bliver mangel på oxygen, anbefales det, at man kun binder knude på plastposen, eller sætter låg på boksen, mens mosprøven transporteres hen til skolen. Resten af tiden skal beholderen gerne være åben.
Tip: Der vokser ofte mos på skyggefulde steder, for eksempel under træer. Fugtige steder, som ved et lille vandløb, plejer også at være gode til at finde mos ved.Observation af bjørnedyr - Det indsamlede mos og eventuelt en lommelygte tages med i skole.
- Som det allerførste, når timen begynder, skal mosset lægges i en beholder og dækkes med vand fra hanen. Det skal gerne stå sådan i minimum en halv time, så bjørnedyrene vågner fra en eventuel dvaletilstand.
- Imens mosset står i vand, gøres stereomikroskoperne klar. De stilles frem, og plastikhætten fjernes, hvis mikroskopet har sådan en på. Der sørges for, at observationsbordet er sort. Nogle stereomikroskoper har en plade i observationsbordet, som kan vendes. Den ene side er typisk hvid og den anden sort. Den sorte side vendes da opad. Hvis ikke mikroskopet har denne egenskab, kan et sort stykke pap placeres på observationsbordet i stedet.
- Lyskilden (eksempelvis en lommelygte) lægges, så den lyser lige ind fra siden. Man kan for eksempel lægge lygten på et par bøger, så den hæves op i den rigtige højde. Hvis stereomikroskopet har egne lyskilder, tændes de.
- Indstil okularerne (de dele på mikroskopet, som man kigger ned i), så afstanden mellem dem passer med afstanden mellem dine øjne.
- Når det indsamlede mos har stået i vand i mindst en halv time tages en petriskål frem. Stil den lige ved siden af beholderen med vand og mos. Tag det våde mos op af beholderen med fingrene, og pres vandet ud af det ned i petriskålen. Læg så mosset tilbage i vandet, tag det op, og pres igen vandet af det ned i petriskålen. Gentag dette, til der er mellem
½ – 1 cm vand i petriskålen. Hvis det går meget langsomt med at fylde petriskålen på denne måde, kan man godt bare hælde lidt vand fra beholderen direkte ned i petriskålen. Det må dog først gøres efter vand er blevet presset ud af mosset omkring fire gange. På den måde får man nemlig nogle af de bjørnedyr, som sidder i mosset, med over i petriskålen. - Fjern større stykker mos fra petriskålen med fingrene. Der skal helst kun være vand og små urenheder i petriskålen.
- Anbring petriskålen med vandprøven på det sorte observationsbord lige under linsen.

Figur 1. Opstillingen til forsøget. Petriskålen placeres på stereomikroskopets observationsbord, og der lyses ind på den fra siden. Lyskilden skal nu lyse direkte ind på petriskålen fra siden.
- Stereomikroskopet indstilles så det forstørrer 30 gange. Vær opmærksom på, at selve okularet (øjenstykket) i sig selv tit forstørrer 10 gange. Der vil så stå 10X på okularet. Hvis det er tilfældet skal selve mikroskopet indstilles til at forstørre 3 gange, fordi 3∙10 = 30 ganges forstørrelse.
- Kig ned i mikroskopet, og stil skarpt. Det gøres ved at dreje på fokusknappen indtil billedet er så skarpt som muligt. Man skal gerne kunne se små bitte stykker mos og jordpartikler, og måske endda små dyr, som bevæger sig rundt. På den sorte baggrund vil levende organismer lyse op som små hvide dele i bevægelse. Man kigger altså ikke direkte på mosprøven, men de dyr i bunden af petrisskålen, der er kommet ud af mosprøven.
- For at finde et bjørnedyr må man væbne sig med tålmodighed – det kan nemlig godt tage noget tid. Der vil måske kun være nogle få bjørnedyr i petriskålen, og et af dem skal findes. Det er en god idé at gå systematisk til værks. Start for eksempel med at lede i venstre side af petriskålen, og bevæg den så frem og tilbage længere og længere mod højre som vist på billedet.

Figur 2. Når man leder efter bjørnedyr, er det en fordel at gå systematisk til værks. Her er der indtegnet et forslag til, hvordan man kan undersøge petriskålen. Da prøven er forstørret omkring 30 gange, vil bare små ryk på petriskålen se meget voldsomme ud i mikroskopet. Bevæg derfor skålen meget forsigtigt rundt. Kig efter små hvidlige dele, som lyser op og bevæger sig. Når petriskålen rykkes rundt, vil bevægelserne i vandet få alt (mos, dyr osv.) til at bevæge sig. Stop derfor nogle gange med at bevæge petriskålen rundt og vent, til mosdelene ligger stille. Man kan på den måde nemt spotte levende dyr. Bjørnedyr bevæger sig på en ret karakteristisk måde, som man kan se efter. I videoen nedenfor vises det, hvordan det kan se ud i stereomikroskopet at lede efter bjørnedyr.
- Når et dyr, som ligner et bjørnedyr, er fundet, zoomer man ind på det ved at dreje på forstørrelsesknappen. Pas endelig på ikke at rykke for kraftigt i petriskålen, så bjørnedyret forsvinder for langt væk fra synsfeltet. Zoom gerne så langt ind, som stereomikroskopet kan, og stil skarpt på dyret. Hvis det er et bjørnedyr, vil man kunne se det bevæge sig rundt med sine otte ben.
- Der kan tages billeder eller videoer af bjørnedyret med et helt almindeligt digitalkamera eller en mobiltelefon. Hold kameralinsen helt ned til okularet (altså den del, som man kigger ned i) og zoom lidt ind på kameraet. Indstil det eventuelt til makrofunktion. Prøv at holde det i forskellige vinkler indtil bjørnedyret kan ses på kameraets skærm. Da bjørnedyret bevæger sig, kan det være nødvendigt at flytte lidt rundt på petriskålen, men det skal gøres meget forsigtigt.
- Der er højst sandsynligt andre dyr end bjørnedyr i skålen, for eksempel hjuldyr og rundorme. De lever ofte sammen med bjørnedyr i mos. Videoerne nedenfor viser, hvordan de ser ud.
- Efter forsøget kan mos og vand godt hældes ud udenfor på noget græs eller jord, hvor det ikke vil genere nogen.
- Mikroskopet pakkes sammen, og der tørres af på bordet.
- En elev fra hver gruppe samler lidt mos (en lille håndfuld er rigeligt) fra en have, en skov eller en park. Det kan typisk findes i græsplæner, på sten eller på træer. Tag gerne mos fra yderkanten af en mospude eller fra de mest grønne områder. Prøv at undgå at få for meget jord med. Det kan gøres ved kun at hive den øverste del af mosset af, når det plukkes eller ved at rive de jordede rødder af bagefter. Den indsamlede mos lægges i en konvolut, en lille plastpose eller en boks. For at der ikke bliver mangel på oxygen, anbefales det, at man kun binder knude på plastposen, eller sætter låg på boksen, mens mosprøven transporteres hen til skolen. Resten af tiden skal beholderen gerne være åben.
Figur 3. En video af, hvordan det ser ud at lede efter bjørnedyr i mikroskopet. Petriskålen bevæges altså bare forsigtigt rundt, og der stoppes op nogle gange. Dette gøres indtil man, som på videoen, finder et bjørnedyr.
Figur 4. Der findes også andre levende organismer i mos. Her ses for eksempel en video af et hjuldyr.
Figur 5. Et andet dyr, som også lever i mos, er rundormen, som ses på videoen her.
Det er denne metode, som jeg selv har brugt til at finde og filme de bjørnedyr, som man kan se i dette materiale.
Enzymer, der er aktive under kolde forhold, har adskillige bioteknologiske anvendelsesmuligheder. Nye smarte og bæredygtige produkter kan nemlig blive udviklet på baggrund af netop kuldeaktive enzymer. Det gælder for eksempel vaskepulver, der kan vaske tøjet rent ved brug af ikke-opvarmet vand. Snavs på tøjet består blandt andet af sukkerstoffer, fedt og proteiner. En af de typer enzymer, som man ofte anvender i vaskepulver, er derfor protease, der nedbryder proteiner. I dette forsøg skal I selv finde bakterier, der producerer kuldeaktive protease-enzymer, og som i teorien vil kunne bruges til produktion af et mere miljørigtigt vaskepulver. Det gør I ved at samle tangplanter fra vandet ved en kyst eller en sø. På tangen lever der et væld af bakterier, som har tilpasset sig det kølige miljø i vandet, og det vil derfor være sandsynligt at nogle af disse bakterier netop producerer kuldeaktive protease-enzymer. Tangplanterne blendes med vand, og blandingen bliver spredt ud på agarplader, sådan at bakterierne kan vokse frem her. Agarpladerne tilsættes skummetmælkspulver, fordi det indeholder proteiner, som protease-enzymerne kan nedbryde. Hvis nogle af de bakteriekolonier, som vokser frem på agarpladerne, danner protease, vil proteinet i skummetmælkspulveret blive nedbrudt i en cirkel rundt om kolonien. Det kan ses som en såkaldt klaringszone, altså en cirkel hvor agaren er blevet gennemsigtig i stedet for grumset hvid. Det kan se ud som på figur 1. Man kan på den måde tydeligt se, hvilke bakterier, der kan være af særlig interesse, hvis man skal lave miljøvenligt vaskepulver.
Forsøget kan med fordel laves i små grupper på 3-4 elever.
Fremstilling af agarplader
Materialer og udstyr
Hver gruppe skal bruge fem agarplader i forsøget. Mængden af plader, der fremstilles, kan tilpasses, så det passer med antallet af grupper. Til ca. 40 agarplader skal der bruges følgende:
- 15 g agarpulver. Det kan med fordel være ”Marine Agar 2216”, som kan bestilles hos Difco (cat. no. 212185), men man kan også sagtens bruge almindeligt agar, som ikke er tilsat næringsstoffer eller salte. Det kan blandt andet købes hos Frederiksen.
- 1 L vand. Brug helst destilleret vand, men almindeligt postevand vil også kunne bruges.
- 20 g skummetmælkspulver. Det kan fås i de fleste supermarkeder.
- 20 g NaCl. Almindeligt køkkensalt kan sagtens bruges. Hvis tangplanterne er indsamlet i en sø, tilsæt da kun 10 g NaCl. NaCl skal helt udelades, hvis man bruger ”Marine Agar 2216”.
- Gryde med låg til kogning af agarblandingen.
- Gasblus eller kogeplade.
- Piskeris til omrøring.
- Ske til at fjerne klumper og skum.
- Ca. 40 stk. petriskåle.
- Plastposer til opbevaring af de færdige agarplader.
- Vægt.
- 1 L måleglas.
Fremgangsmåde
Denne del af forsøget kan læreren eventuelt lave forud for undervisningen. Agarpladerne kan sagtens laves nogle dage i forvejen, hvis de blot opbevares med bunden opad i plastposer i et køleskab, indtil de skal bruges.
- Afvej agar, skummetmælkspulver og eventuelt salt, og bland det med 1 L destilleret vand i en gryde.
- Før der tændes for varmen, røres klumperne forsigtigt ud. Brug gerne en ske til at fjerne de sidste små klumper ved at mase dem op ad grydens side.
- Opvarm forsigtigt blandingen på et gasblus eller en kogeplade. Det er vigtigt, at der røres relativt forsigtigt så skumdannelsen mindskes mest muligt. Dog skal der en næsten konstant omrøring til, for at blandingen ikke brænder fast i bunden. Når agaren er smeltet, og blandingen er ensartet, skrues der op for varmen, så blandingen lige kommer op at koge. Hold hele tiden øje med gryden, for det koger let over. Lad den ikke koge i mere end et par minutter, da der ellers fordamper for meget vand fra gryden. Det er dog vigtigt, at blandingen kommer op og koge, så de fleste mikroorganismer dør. For at gøre processen så enkel som muligt autoklaveres pladerne nemlig ikke. Det er derfor samtidigt vigtigt at være omhyggelig med ikke at udsætte agarblandingen for unødig kontakt med omgivelserne.
- Sluk for varmen, og fjern med en ske det meste af skummet, der er dannet på overfladen af blandingen. Det er godt at få så meget af skummet med som muligt, fordi man på den måde mindsker mængden af luftbobler i de færdige agarplader.
- Lad eventuelt agarblandingen køle lidt af under låg, hvis den stadig er kogende – men lad den ikke køle for længe, for så begynder agaren at blive tyktflydende.
- Fordel agarblandingen i petriskåle, så det dækker bunden, og tykkelsen af agarlaget er omkring en halv centimeter. Der burde være til omkring 40 stykker. Pas på ikke at brænde dig på den varme agar.
- Lad pladerne stivne i omkring 15 min. med lågene sat skråt på, så der er en lille sprække åben. På den måde minimeres mængden af kondens.
- Opbevar de færdige plader med låg på og bunden opad i plastposer i køleskabet.
- Tag dem ud i stuetemperatur ca. en time før brug, så de lettere optager blandingen af vand og tang. Lad dem eventuelt tørre i en LAF-bænk med lågene halvt på.
Indsamling og dyrkning af bakterier
Materialer og udstyr
- Plastpose eller beholder med låg til indsamling af tangplanter.
- Frisk tang indsamlet i havet eller en sø. Der skal kun bruges en lille smule, så en håndfuld er rigeligt til alle grupperne.
- Lidt vand fra indsamlingsstedet – fyld posen eller boksen med tangplanterne med hav- eller søvand. Der skal teoretisk set bruges mindre end 100 mL i alt, men det er fint at have noget i overskud.
- Fem agarplader med skummetmælkspulver til hver gruppe (lavet i forvejen ud fra forskriften ovenfor).
- Blender, foodprocessor eller lignende.
- Pipette (100 µL til 1000 µL) til hver gruppe.
- Fem eppendorfrør, reagensglas eller falkonrør til hver gruppe.
- Tre kaffefiltre til filtrering.
- Tragt til filtrering.
- Bægerglas eller lignende til den filtrerede tangblanding.
- Ethanol.
- Lille bægerglas til hver gruppe til ethanol.
- Bunsenbrænder til hver gruppe.
- Køleskab.
- Sprittusser til at skrive på petriskålene.
- Drigalskispatel til hver gruppe til udpladning på agarpladerne.
Fremgangsmåde
Indsamling af tangplanter
- Indsaml tangplanter fra vandet ved en kyst eller en søbred, og opbevar dem i en plastpose eller boks fyldt med vand fra indsamlingsområdet. Ved længere tids opbevaring, eksempelvis natten over, skal tangplanterne i køleskabet. Det er ikke selve tangplanten, vi er interesseret i, men snarere de mange bakterier, der lever på dem. Disse bakterier lever nemlig i et relativt koldt miljø, og man kan derfor forestille sig, at de producerer enzymer, der er virksomme ved temperaturer lavere end de 30 °C til 40 °C, som vi normalt vasker tøj ved.
- Dette, samt næste trin, kan med fordel gøres samlet for hele klassen. Blend en lille tot af tangplanterne og lidt af det tilhørende vand, så det bliver til en så ensartet blanding som muligt. Det vil dog ofte være umuligt at få blandingen helt ensartet. Blandingen skal imidlertid være tynd og finblendet nok til at kunne passere igennem et kaffefilter. Der skal gerne være så meget vand i forhold til tang, at det bliver meget tyndtflydende. Der skal bruges under 10 mL tangblanding i alt, men blend gerne et større volumen, så det er nemmere at arbejde med. Brug dog ikke alt hav- eller søvandet, for der skal være minimum 50 mL tilbage i alt til de fortyndingsrækker, grupperne laver senere.
- Filtrer de tilbageblevne tangstykker fra ved at lade blandingen passere gennem tre kaffefiltre, som er sat oven i hinanden i en tragt. Opsaml den filtrerede væske i et rent bægerglas.
- Hver gruppe får et eppendorfrør med 1 mL filtreret tangblanding. Herpå skrives 100 med en sprittus. Denne notation betyder, at tangblandingen ikke er fortyndet, da 100 = 1.
- I grupperne laves der en fortyndingsrække ud fra den ufortyndede tangblanding, altså ud fra 100-røret.

Figur 2. Fremgangsmåde for at lave en fortyndingsrække af den filtrerede tangblanding. Det gøres på følgende måde: Klargør fire rør og skriv 101, 102, 103 og 104 på dem med sprittus. I 101-røret vil tangblandingen blive 101 =10 gange fortyndet, i 102-røret vil blandingen blive 102 = 10∙10 = 100 gange fortyndet, i 103-røret vil det være 103 = 10∙10∙10 = 1000 gange fortyndet og i 104-røret vil den oprindelige tangblanding blive 104 = 10∙10∙10∙10 = 10.000 gange fortyndet. Selve fortyndingen laves ved at starte med at komme 0,9 mL = 900 µL hav- eller søvand i hvert af de fire rør (101, 102, 103 og 104) med en pipette. Der overføres nu 0,1 mL = 100 µL af tangblandingen fra 100-røret til 101-røret, og der blandes grundigt ved at røre rundt med pipettespidsen. Derefter tages 0,1 mL = 100 µL fra 101-røret og overføres til 102-røret, og der blandes igen. På samme måde overføres 0,1 mL = 100 µL fra 102-røret til 103-røret, og efter en grundig omrøring overføres der fra 103-røret til 104-røret. For hver overførsel mellem rørene fortyndes der altså 10 gange. Jo mere man fortynder, desto færre bakterier er der til stede. Husk at skifte pipettespids mellem hver overførsel. Fremgangsmåden kan desuden ses i figur 2.
- Gør fem agarplader klar. Skriv fortyndingerne 100 til 104 og gruppenavn eller -nummer på bunden af petriskålene. Skriv aldrig på lågene, da de ved en fejl kan komme til at blive byttet rundt.
- Hæld en smule ethanol op i et lille bægerglas, find en drigalskispatel frem, og tænd bunsenbrænderen.
- Kom omkring 100 µL af 100– fortyndingen ud på den tilhørende agarplade. Det svarer nogenlunde til en stor dråbe.
- Dyp drigalskispatelen ned i ethanol, og hold den meget kort ind i flammen fra bunsenbrænderen for at antænde ethanolen. Dette sikrer, at der ikke sidder uønskede bakterier på spatelen.
- Lad spatelen køle ned i ca. 10 sekunder uden at den rører ved noget.
- Fordel væsken rundt på agarpladen med drigalskispatelen. Bliv ved med at stryge spatelen rundt, til agaren har optaget al tangblandingen, og den derfor føles tør, når man bevæger spatelen rundt. Læg låg på pladen, så snart den er færdig.
- Gentag trin 8-11 for de andre fortyndinger.
- De fem petriskåle med tangblandingerne stables med bunden opad og kommes i en plastpose. Det er meget vigtigt at petriskålene vendes sådan, at bunden med agaren er opad. Hvis der dannes kondens inde i petriskålen, vil det nemlig løbe ned i låget i stedet for at havne på agaren og ødelægge bakteriekolonierne, som vokser her.
- Stil pladerne ved stuetemperatur. Det anbefales dog, at det er et køligt sted, hvor temperaturen ikke pludselig stiger, fordi solen for eksempel står direkte ind på.Den efterfølgende uge
- For at pladerne ikke bliver overgroet af bakterier, og klaringszonerne derfor ikke ses tydeligt, er det en god idé at kigge til agarpladerne hver dag. Det vil dog sandsynligvis tage fire til syv dage, før der har været en tilstrækkelig bakterievækst, så mange tydelige kolonier og – forhåbentlig – klaringszoner kan ses. Når dette stadie nås, sættes pladerne i køleskabet, for at bremse væksten indtil de skal undersøges.Observationsdag
- Kig på jeres fem agarplader. Er der nogle af bakteriekolonierne, som har dannet protease-enzymer, og som man derfor kunne se nærmere på ved fremstilling af miljøvenligt vaskepulver?
Diskussionsspørgsmål til forsøget
Ud fra afsnittet om psykrofile bakterier i teoridelen vil I så tro, at de bakterier, som vokser frem på agarpladerne, kan kategoriseres som psykrofile eller psykrotolerante bakterier?
I dette forsøg har det været formålet at undersøge, om nogle af bakterierne fra de indsamlede tangplanter producerer protease-enzymer. Tror I, at det kun er bakterier fra tangplanterne, som I ser på agarpladerne? Hvis ikke, hvor kunne de øvrige bakterier på pladerne så komme fra?
Diskuter spørgsmålene to og to eller i mindre grupper, og skriv jeres svar ned. Husk en begrundelse.
Kildehenvisning:
Dette projekt blev udgivet i november 2018. Det er udarbejdet af Biotech Academy og er blevet opdateret løbende.

Projektet er udarbejdet af Pi Westi Bondegaard.
Pi læser til civilingeniør i Bioteknologi.
Læs mere om Pi her.
Pi Westi Bondegaard

Mariane Schmidt Thøgersen er postdoc på Danmarks Tekniske Universitet på Institut for Systembiologi. Mariane har været sparingspartner på materialet om ekstremofile bakterier.
Mariane Schmidt Thøgersen

Reinhardt Møbjerg Kristensen har siden 1996 været professor ved Statens Naturhistoriske Museum. Reinhardt har været sparingspartner på materialet om bjørnedyr.
Reinhardt Møbjerg Kristensen

Institut for Systembiologi har Danmarks største biovidenskabelige og bioteknologiske forskning på universitetsniveau. Instituttet har været partner og sponsor på projektet.
Institut for Systembiologi

“Folkeskolen skal udfordre alle elever, så de bliver så dygtige, de kan. Samtidig skal folkeskolen mindske betydningen af social baggrund i forhold til faglige resultater samt øge elevernes trivsel.” Ministeriet har støttet projektet.

